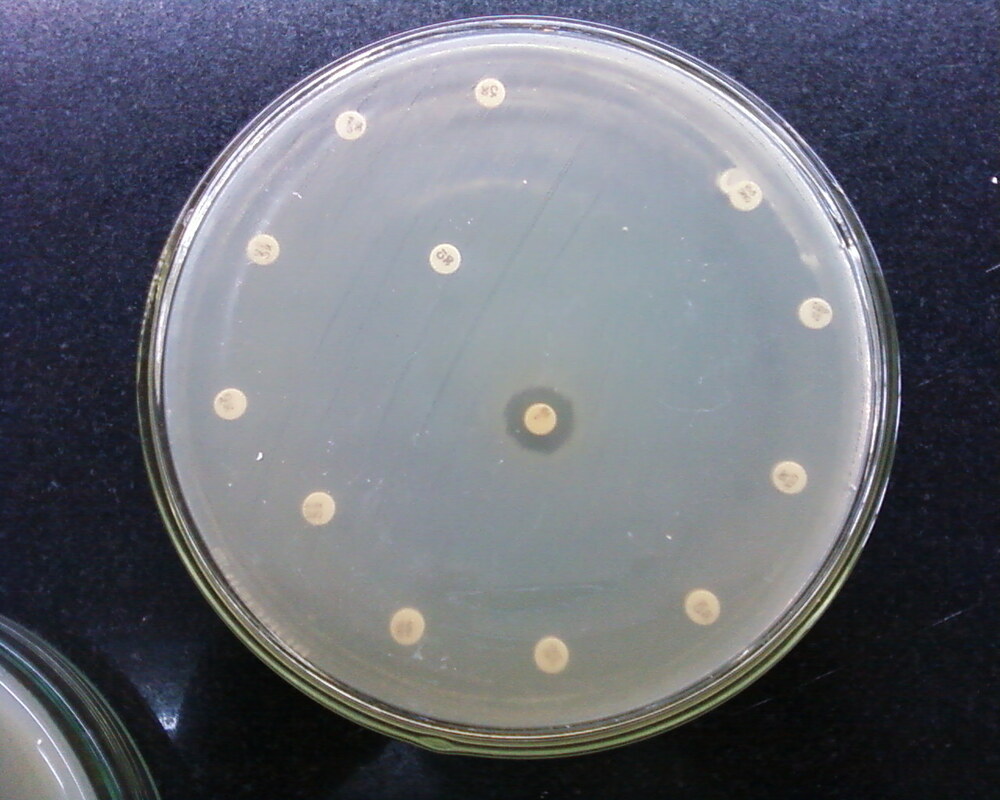
Новый метод оценивает эволюционные риски антибиотиков

Исследователи разработали математическую модель, которая может помочь врачам выбрать антибиотики, минимизирующие лекарственную резистентность.
Поскольку разработка новых антибиотиков для лечения инфекций продвигается слишком медленно, многие пациенты теперь получают лечение несколькими препаратами в надежде, что их совместное терапевтическое воздействие сможет предотвратить дальнейшее развитие резистентности. Однако такое лечение сопряжено со многими рисками и неизвестными факторами.
Давая пациенту один препарат, бактерии часто развивают резистентность к нему. К счастью, некоторые из этих резистентных мутантов становятся более восприимчивыми ко второму препарату, что позволяет врачам успешно лечить инфекцию. Однако врачи не всегда могут быть уверены, что эволюция пойдет таким удачным путем. Хуже того, резистентность к первому препарату может привести к обратному результату и вызвать рост резистентности ко второму препарату, в результате чего у врачей не останется никаких вариантов дальнейшего лечения.
Ученые Калифорнийского университета разработали метод, который может помочь врачам рассчитать вероятность благоприятного исхода для различных пар лекарственных препаратов и тем самым повысить шансы на успешное лечение. В журнале eLife описана математическая модель, которая может рассчитать риск эволюции резистентности для различных пар препаратов.
"Проблема использования нескольких препаратов для лечения бактерий заключается в том, что мы просто не знаем, какие мутации доступны бактериям", - говорит соавтор работы Сергей Кряжимский. "Во многих ситуациях бактерии могут мутировать, что делает их резистентными к обоим препаратам, или мутировать так, чтобы стать резистентными к первому препарату, но восприимчивыми ко второму. В таких ситуациях очень трудно предсказать, в какую сторону будет развиваться популяция. Разработанная нами модель позволяет делать такие прогнозы".
При разработке модели Кряжимский использовал новую концепцию JDFE (joint distribution of fitness effects - совместное распределение фитнес-эффектов (новых мутаций)). JDFE характеризует различные виды мутаций, доступных бактериям, и позволяет исследователям классифицировать пары препаратов на те, которые способствуют или препятствуют развитию множественной лекарственной резистентности.
Изучив мутационные данные Escherichia coli, исследователи обнаружили множество мутаций резистентности к различным широко используемым антибиотикам, которые приводят к побочной чувствительности (благоприятный исход) или побочной резистентности (неблагоприятный исход) к другим препаратам. По их словам, их новая модель может помочь лучше предсказывать развитие резистентности, что означает преимущество для инфицированных пациентов, хотя она и не является надежной, учитывая неизбежную случайность эволюции.
По словам Кряжимского, он была удивлен, узнав, что резистентность к антибиотикам не может рассматриваться как простой детерминированный процесс. Чем больше он узнавал, тем больше становилось ясно, что различные популяции бактерий развивают резистентность по-разному, даже в контролируемых лабораторных условиях. Одни и те же эксперименты, проведенные в разных лабораториях, часто давали противоречивые результаты. Штамм бактерий, концентрация антибиотиков и питательные вещества в окружающей организм среде - все это может привести к неоднозначным результатам.
"Но даже если все эти вещи абсолютно одинаковы, вы все равно можете получить разные результаты в двух разных итерациях просто потому, что эволюция накапливает случайные мутации", - говорит Кряжимский. "В двух разных популяциях могли случайно накопиться разные мутации с разными побочными эффектами, даже если все остальное одинаково. В этих процессах так много изменчивости и случайности, и это невероятно важная вещь, о которой нужно думать в интересах пациентов. Мы хотим давать пары препаратов, в которых мы уверены, что они, насколько это возможно, будут давать побочную чувствительность - и не только в 50 % случаев".
Исследователи отмечают, что еще многое предстоит узнать о разнообразии побочных эффектов мутаций резистентности. В настоящее время Кряжимский и коллеги изучают пары препаратов, воздействующих на одну и ту же мишень - рибосому, важный белковый комплекс в бактериальных клетках и строит метаболическую модель клетки, чтобы понять JDFE с механистической точки зрения.
"Суть нашего результата заключается в том, что мы можем предсказать вероятность развития сопутствующей резистентности",
- говорит Кряжимский. "Это не идеально, но это предпочтительнее, чем вообще не иметь представления о том, что произойдет. Если мы тщательно подберем пары препаратов, мы сможем минимизировать вероятность развития побочной резистентности. Мы не можем полностью исключить неблагоприятный исход, но мы можем минимизировать вероятность того, что он произойдет. Наша работа может в конечном итоге помочь клиницистам выбирать препараты, которые минимизируют эволюцию множественной лекарственной резистентности".